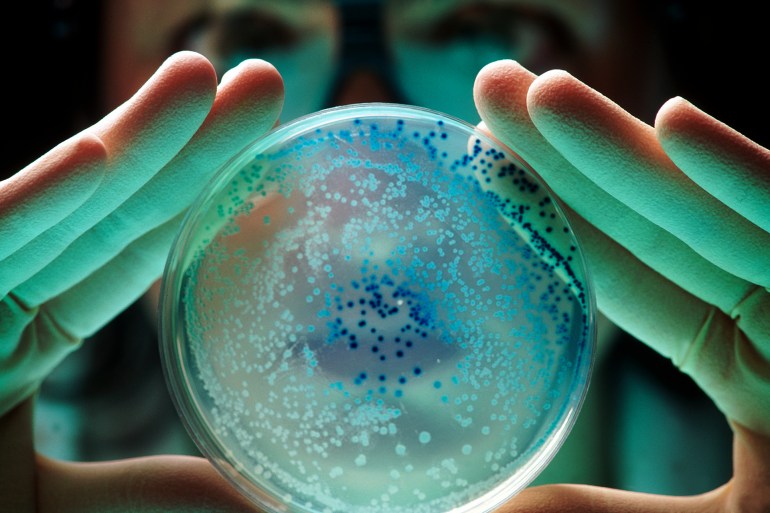
gettyimages-521677434 escherichia bacteria

تعد الإضافات الغذائية جزءا أساسيا من صناعة الأطعمة المعالجة وتستخدم لتحسين المذاق والملمس وإطالة فترة الصلاحية، وتكشف أبحاث حديثة أن بعض هذه المواد قد تضر بتوازن ميكروبات الأمعاء، مما يسبب مشكلات صحية قد تمتد إلى الدماغ.
والإضافات الغذائية هي مواد تضاف إلى الأطعمة خلال مراحل الإنتاج والتعبئة والتغليف، وذلك لتحسين المذاق، أو اللون، أو القوام، أو الحفاظ على المنتج لفترة أطول. وقد تكون هذه الإضافات طبيعية مثل الملح والفلفل، أو اصطناعية كالأصباغ الصناعية والمنكهات.
وفي تقرير نشرته مجلة “سايكولوجي توداي”، قال الكاتب سكوت سي أندرسون إن إدارة الغذاء والدواء الأميركية تشترط إجراء دراسة سلامة قبل الموافقة على المواد المضافة الغذائية الجديدة، ولكن إجراءاتها لا تتضمن اختبار تأثيرات تلك المواد على ميكروبات الأمعاء، وهذا يعد خطأ كبيرا.
واعتبر الكاتب أننا بحاجة إلى نهج جديد للتعامل مع الإضافات الغذائية من خلال اختبار تأثيرها على الميكروبات المعوية المفيدة والتأكد من أن تلك المواد لا تقضي على الميكروبات، أو تعزز مسببات الأمراض، وهو الأمر الأسوأ، على حد تعبيره.
وأضاف أن عددا من الباحثين يعملون حاليا على دراسة هذه التأثيرات السلبية، وكانت النتائج التي توصلوا إليها مثيرة للقلق. ومن بين تلك الجهود، دراسة حديثة أجراها البروفيسور لي-يان شين وزملاؤه من جامعة تايوان الوطنية، وأظهرت أن العديد من المستحلبات، وخاصة الصناعية منها، تسبب تغييرات في ميكروبيوم الأمعاء.
والمستحلبات هي مواد مضافة تساعد على امتزاج الزيت والماء، وتمنح الطعام ملمسا ناعما يفضله المصنعون، وتوجد في عدد كبير من الأطعمة المعالجة، من بينها زبدة الفول السوداني والخبز والسجق والآيس كريم.
وذكر الكاتب أن الباحثين وجدوا أن المستحلبات تساعد البكتيريا على غزو طبقة المخاط المحيطة بالأمعاء. ويعدّ المخاط خط الدفاع الأول ضد الميكروبات الضارة، وعندما يتعرض للتلف يصبح من الأسهل على هذه الميكروبات وسمومها المرور عبر جدار الأمعاء والدخول إلى مجرى الدم.
وقد وجد الباحثون دلائل على تسبب المستحلبات فيما يُعرف بالالتهاب الجهازي (وهو الاستجابة البيولوجية النموذجية بعد الإصابة بالعدوى والأمراض الالتهابية المزمنة)، بالإضافة إلى زيادة في الاضطرابات الأيضية، بما في ذلك ارتفاع مستويات السكر في الدم ومقاومة الأنسولين.
وأضاف الكاتب أن هذه النتائج تتماشى مع دراسة سابقة أجراها بينوا شاسينغ وزملاؤه في جامعة باريس، حيث وجدوا تأثيرا مشابها لاثنين من المستحلبات الصناعية، وهما “بوليسوربات 80″ و”كاربوكسي ميثيل سليلوز”. وقد ثبت أن هاتين المادتين أسوأ من غيرهما في التأثير على توازن ميكروبيوم الأمعاء وتعزيز الالتهابات.
التأثيرات على الدماغ
من جانب آخر، وجدت دراسة حديثة أجراها بينغ لي وزملاؤه في جامعة تيانجين الطبية أن المستحلبات قد تؤدي إلى تدهور الإدراك. على وجه التحديد، تسببت مادة “بوليسوربات 80” في تعطيل الحاجز الدموي الدماغي، مما أدى إلى تراكم السموم في الدماغ.
وتم إجراء هذه الدراسة على الفئران، لكن الباحثين أشاروا إلى أنها “تقدم دليلا قويا على أن خلل ميكروبيوم الأمعاء الناتج عن النظام الغذائي قد يكون عاملا خطرا يؤدي للتدهور المعرفي المرتبط بالتقدم في السن”.
وذكر الكاتب أن هناك دراسة أخرى أجراها شاسينغ وزملاؤه، أظهرت أن المستحلبات أثّرت على سلوك الفئران، فقد أظهر الفئران الذكور مستويات عالية من التوتر، وأظهرت الإناث قدرا من الانطوائية.

نتائج مثيرة للقلق
وجدت دراسة جديدة -أجرتها جيسيكا فيتزباتريك وزملاؤها في جامعة موناش الأسترالية- أن الأشخاص غير المجهدين كانوا قادرين على التعامل بشكل جيد مع المستحلبات، بينما ظهرت زيادة في نفاذية الأمعاء لدى الأشخاص المجهدين، مماثلة لتلك التي لوحظت في الدراسات على الفئران.
وحسب الكاتب، فإن هذه النتائج مثيرة للقلق، لأن نفاذية الأمعاء أو ما يُعرف أيضا بـ”الأمعاء المتسربة” هذه يمكن أن تزيد من القلق والتوتر، مما يعني الدخول في حلقة مفرغة ما بين الإجهاد والمشاكل المعوية عند تناول المستحلبات.
لكنه أوضح أن الأمر لا ينطبق على جميع المستحلبات، حيث إن الصناعية منها هي التي تضر بالأمعاء وفق ما كشفته الدراسات، لكن المستحلبات الأخرى المستخدمة في الأطعمة منذ وقت طويل، مثل الليسيثين الموجود في البيض وعباد الشمس، يمكن تحملها بشكل جيد.
تجنب هذه المستحلبات الصناعية
لتجنب التأثير السلبي للمستحلبات على الميكروبات المفيدة وما قد يؤدي إليه ذلك من أمراض مزمنة، مثل أمراض القلب والسكري والخرف والسرطان، ينصح الكاتب بالابتعاد عن المستحلبات الصناعية مثل “بوليسوربات 80″ و”كاربوكسي ميثيل السليلوز”.
ويؤكد أن الأفضل هو تناول المزيد من الأطعمة غير المعالجة مثل الخضروات والفاكهة، لأنها تحتوي على كمية كبيرة من الألياف التي تعزز صحة الأمعاء.